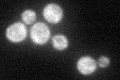
YPR129W
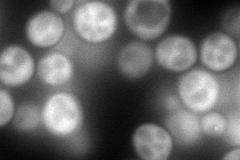
YPR129W
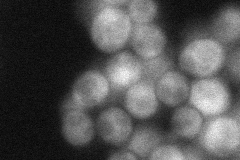
YPR129W
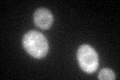
YPR129W
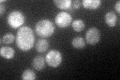
YPR129W

View description
Protein containing an Lsm domain, may bind RNA and have a role in RNA processing; overproduction suppresses a null mutation in CHC1, which encodes the heavy chain of clathrin
Localization:
Intensity:
Fold change:
Significance:
-
C’ GFP library in SD
cytosol46.61 -
N' NOP1pr-GFP in SD
cytosol,punctate218.689 -
N' TEF2pr-mCherry in SD

punctate229.307 -
N' NATIVEpr-GFP in SD
cytosol53.7759 -
N' TEF2pr-VC and Cyto-VN in SD

#N/A0 -
C’ GFP library in SD+DTT
cytosol44.060.94No -
C’ GFP library in SD+H2O2

punctateN/AN/ANo -
C’ GFP library in Starvation Media
cytosol75.791.62Yes -
C’ GFP library on the background of Pup2-DaMP

cytosol -
C’ GFP library on the background of CCT mutant

cytosol49.63171.06477No
